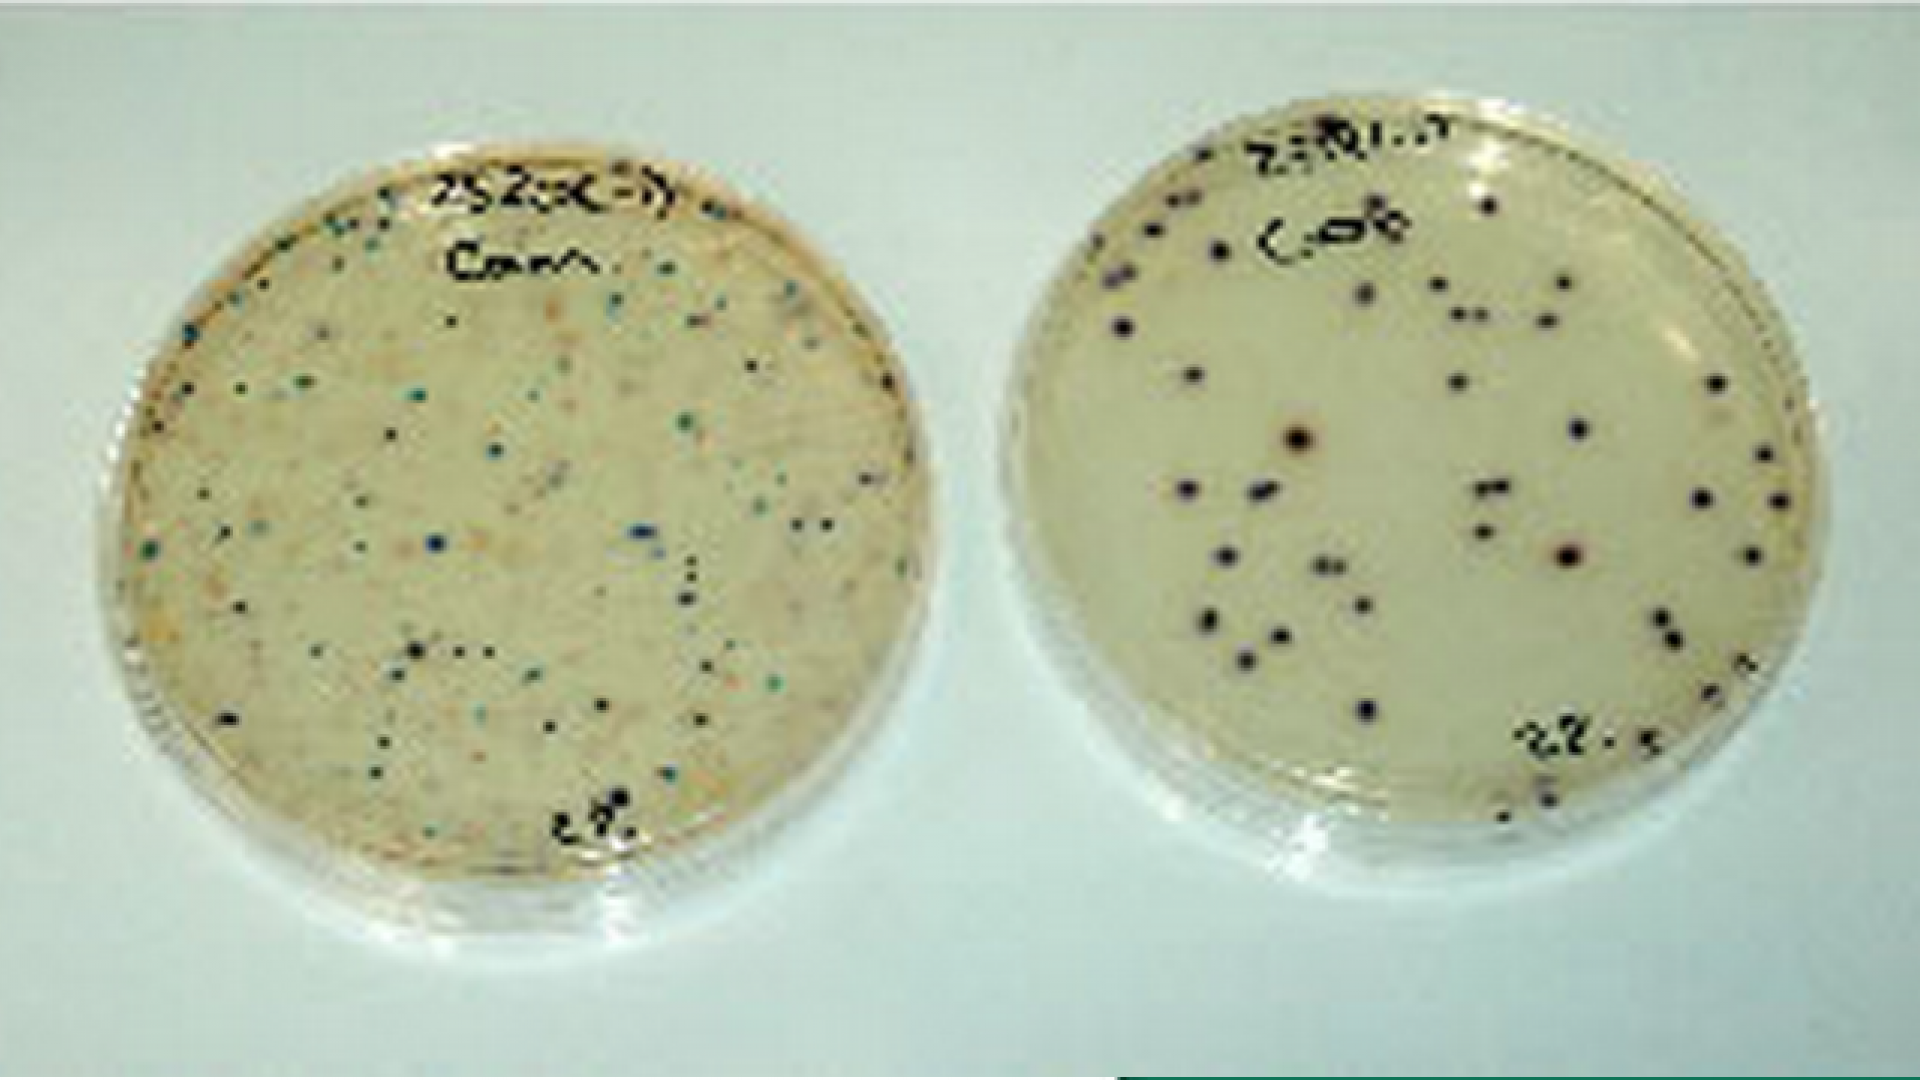

CALIDAD
Evaluación de calidad microbiológica
Después de la limpieza y envasado, todos los implantes son esterilizados mediante irradiación gamma. La evaluación microbiológica posterior permite demostrar la no presencia de bacterias y hongos.
(Informe: 832/10)
Determinación de endotoxinas o LAL test según USP demostrando la idoneidad del producto sanitario.
(Informe: S-2014-03633 AMi)